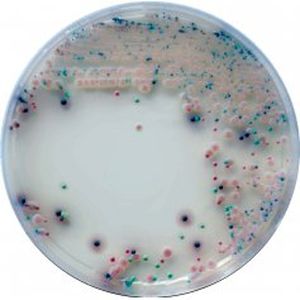

Кандида В Слюне

👉🏻👉🏻👉🏻 ВСЯ ИНФОРМАЦИЯ ДОСТУПНА ЗДЕСЬ, ЖМИТЕ 👈🏻👈🏻👈🏻
кандида в слюне что делать
Обнаружена кандида в слюне — 1 ответ инфекциониста на . . .
Кандида в слюне симптомы - dombeetchim .ru
Кандида, определение ДНК (Candida albicans, DNA) в слюне . . .
КАНДИДОЗ: Простой способ проверить наличие грибка в организме
Кандида, определение ДНК (Candida albicans, DNA) в слюне . . .
Подозреваете у себя кандидоз? Простой способ проверить . . .
Вот простой способ узнать, есть ли у вас кандидоз | nakonu .com
Домашний тест на наличие грибка кандида в организме и . . .
ПРОСТОЙ ДОМАШНИЙ ТЕСТ НА НАЛИЧИЕ ГРИБКА КАНДИДА В . . .
Вальдоксан Побочные Действия
Инфанрикс Гекса Инвитро
Мазь Индометацин Побочные Действия
кандида в слюне что . . . Увеличиваясь в размерах, «крупинки» превращаются в бляшки, которые, в свою очередь, сливаются, образуя сплошные белые пленки .
Хронические болезни: Гастрит, кисты печени, деформация желчного пузыря, пневмотоз ободочной кишки, диффузные изменения поджелудочной железы . Кандида в слюне . 500 .00 р . На сервисе СпросиВрача доступна консультация инфекциониста по любой волнующей Вас проблеме .
Кандида в слюне симптомы Симптомы Автор admin На чтение 17 мин Просмотров 4 Опубликовано 10 апреля, 2021
В лаборатории Инвитро вы можете сдать анализ Кандида, определение ДНК (Candida albicans, DNA) в слюне, узнать стоимость исследования в Москве, сроки выдачи результатов с расшифровкой нормы, сколько стоит взятие биоматериала
Если слюна плавает на поверхности, это означает, что кандидоз, вероятнее всего, не представляет собой проблему . Если слюна ниточками спускается вниз, или мутные частицы остаются во взвешенном состоянии, то, возможно, у вас есть проблемы с размножением грибка кандида, которая влияет на ваше общее состояние здоровья .
Сдать анализ «Кандида, определение ДНК (Candida albicans, DNA) в слюне» в Минске в медицинской лаборатории ИНВИТРО, стоимость исследования, сроки выдачи результатов с расшифровкой нормы, сколько стоит взятие биоматериала
Если слюна плавает на поверхности, это означает, что кандидоз, вероятнее всего, не представляет собой проблему . Если слюна ниточками спускается вниз, или мутные частицы остаются во взвешенном состоянии, то, возможно, у вас есть проблемы с размножением грибка кандида, которая влияет на ваше общее состояние здоровья .
Наблюдайте за изменениями в слюне в стакане через 15-30 минут и запишите свой результат . Если слюна плавает на поверхности, это означает, что кандидоз, вероятнее всего, не представляет собой проблему .
Тест на определение уровня грибка кандида существует уже достаточно давно, его происхождение определенно неизвестно, однако считается, что он весьма точен и результатам вполне можно доверять . 1 . Когда вы с утра проснулись и еще не успели ничего съесть или выпить, наберите во рту немного слюны и плюньте в стеклянный стакан с водой . 2 .
Если в вашем теле чрезмерно быстрое распространение кандидоза, это будет видно по слюне — благоприятной среде для дрожжей . Когда вы плюёте в стакан, слюна с воздухом легче, чем вода . А дрожжи ещё тяжелее . Если со слюны свисают «ноги», плавают мутные частички или мутная слюна — это всё признаки кандидоза .
Ингарон Цена Саратов
Жидкий Хофитол Для Детей Отзывы
Инсулин Ринлиз Инструкция
Дексаметазон Сколько Мл В Ампуле
Ректуар Свечи Или Витапрост
Город Мирный Архангельская Область Работа Охранником
Феринжект Цена Капельница Цена В Аптеке
Дюфалак Производитель
Конкор 2 5 От Чего Помогает
Периндоприл Вертекс
Лазолван Форма Выпуска Для Ингаляций
Сирдалуд Зависимость
Метглиб Аналоги
Овестин Гель
Био Мемори Гинкго Ампулы Отзывы
Эстровагин Отзывы
Что Лучше Солпадеин
Кансалазин Свечи
Гидрокортизон В Ампулах Для Ингаляций
Велферрум Отзывы
Пимафуцин Мазь
Артровир Или Мукосат
Сереброff Раствор Протаргола
Инъектран Уколы Аналоги Дешевле Название
Мельдоний Канон Отзывы
Опухло Бедро После Пентаксима
Вессел Дуэ Ампулы Самара
Пантовигар Витамины Таблетки Для Волос Цена
Циндолом Мазь Инструкция Цена
Фосфомицин Порошок 3 Г Отзывы
Голдлайн 30 Таблеток Цена
Гиоксизон Рлс
Нимесил При Зубной Боли Взрослым
Бронходилататоры Сальбутамол
Дипроспан После Дексаметазона
Ацекардол Можно Заменить Кардиомагнилом
Таблетки Для Поднятия Гемоглобина Сорбифер
Депакин Гормональные Или Нет
Ибуклин Ребенку 15 Лет
Примадофилус Инструкция По Применению Взрослым
Спазган При Давлении И Головной Боли
Температура После Пирантела У Ребенка Форум
Сколько Стоит Эссенциале Форте
Лекарственным Сырьем У Элеутерококка Является
Эритромицин 500 Отзывы
Утрожестан Прогинова При Беременности
Пью Визанну Идут Месячные Это Нормально
Селмевит Инструкция Отзывы
Контрактубекс Цена В Москве Аналоги Дешевле
Г Челябинск Лекарство Глаупрост Цена В Аптеке
Энтерофурил При Цистите
Мексидол 5 0 Внутримышечно
Нурофен После Цефекона
Эритромицин Наружное Применение
Лазолван Для Ингаляций Показания К Применению
Кофе Джардинс Светлая Обжарка Цена
Чем Отличается Элевит От Элевит Кормление
Сколько Стоят Таблетки Моксонидин Канон
Диклофенак Показания К Применению
Дексонал Уколы Цена Отзывы Аналоги
Резистентны К Нифуроксазиду
Кетотифен Зубная Боль
Дихромат Натрия И Йодид Калия
Эффекс Силденафил Таб Инструкция Цена
Обезболивающая Мазь На Основе Лидокаина
Гнойные Миндалины Лечение
Ливарол Свечи Кровянистые Выделения
Аналог Тизина Для Детей
Как Ставить Уколы Дексаметазона Внутримышечно
Снотворное Валемидин Цена
Кетокам От Чего Помогает
Персен Таблетки Побочные Действия
Витапрост 100мг
Ноотропил Курс Лечения Сколько
Продленный Нифедипин
Полидекс Гелабон Отзывы
Противозачаточные Таблетки Новинет Отзывы
Лекарство Дуодарт Цены В СПб И Ленинградской
Метиленовый Синий Беременным
Мелоксикам Обл Таблетки
Д Пантенол С Какого Возраста
Детралекс При Геморроидальных Узлах Отзывы
Лютеин Форте 500мг
Лазолван При Сухом Кашле У Ребенка Форум
Селен 6 Солгар Отзывы
Спазмалгон Эффект Аналог
Примадофилус Реутери Аналоги
Омник Инструкция Цена Отзывы Аналоги
Кипферон 125
Бусерелин Второй Укол Отзывы
Жанин При Миоме Отзывы
Кеторолак Уколы Цена
Полидекса Отзывы Взрослых Для Носа
Препарат Гемодез
Канефрон 120 Цена
Ревмарт Или Мелоксикам Что Лучше
Цетрин Когда Принимать Утром Или Вечером
Клостилбегит Для Чего Женщинам При Планировании Беременности
Нобазит При Короновирусе Отзывы
Офлоксацин Таблетки 500
Кандида В Слюне




















































/imgs/2019/08/05/10/3481882/4629541b8ecdb598d706895d356667f729cdd5b8.jpg)